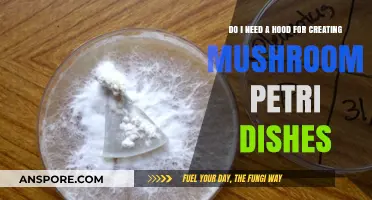
Mushroom Petri Dish Setup: Is a Hood Essential for Success?

When cultivating oyster mushrooms, pasteurizing straw is a crucial step to ensure a successful and healthy harvest. Pasteurization involves treating the straw with heat to eliminate competing microorganisms, pests, and pathogens that could hinder mushroom growth. While it is possible to use untreated straw, pasteurization significantly reduces the risk of contamination, creating a more favorable environment for the mushroom mycelium to thrive. This process also helps break down the straw’s lignin, making it easier for the mycelium to colonize. For beginners or those seeking consistent results, pasteurizing straw is highly recommended, as it minimizes potential issues and maximizes the chances of a bountiful oyster mushroom yield.
Explore related products
What You'll Learn

Pasteurization vs. Sterilization
When cultivating oyster mushrooms on straw, understanding the difference between pasteurization and sterilization is crucial for successful growth. Pasteurization involves heating the straw to a specific temperature (typically around 60-70°C or 140-158°F) for a certain duration to reduce the population of competing microorganisms without killing all of them. This process retains some beneficial microbes while eliminating harmful pathogens that could outcompete the mushroom mycelium. Sterilization, on the other hand, is a more aggressive process that uses higher temperatures (usually above 121°C or 250°F) to kill all living organisms, including bacteria, fungi, and spores. For oyster mushrooms, pasteurization is generally sufficient because these mushrooms are robust and can compete with the remaining microbes, whereas sterilization is often unnecessary and can be more resource-intensive.
Pasteurization is the preferred method for straw used in oyster mushroom cultivation because it strikes a balance between reducing contaminants and preserving the straw's structure and nutrients. The process typically involves soaking the straw in hot water or using a pasteurization tunnel. This method is cost-effective, energy-efficient, and easier to implement compared to sterilization. Additionally, pasteurized straw still contains some microorganisms that can contribute to a healthy substrate ecosystem, aiding in the breakdown of lignin and cellulose, which oyster mushrooms thrive on. Sterilization, while thorough, can make the straw too clean, potentially depriving the mycelium of the microbial activity it needs to grow optimally.
Sterilization is more commonly used in laboratory settings or for cultivating mushrooms that are highly sensitive to contamination, such as shiitake or reishi. For oyster mushrooms, however, the benefits of sterilization rarely outweigh the costs and effort involved. Sterilizing straw requires specialized equipment like an autoclave and consumes more energy due to the higher temperatures needed. Moreover, over-sterilization can lead to the straw becoming too compact or lacking the microbial activity necessary for efficient colonization by oyster mushroom mycelium.
In practice, pasteurizing straw for oyster mushrooms involves a few straightforward steps. First, chop the straw into manageable lengths (around 5-10 cm) and soak it in hot water at 65-70°C for 1-2 hours. Alternatively, you can use a pasteurization tunnel if available. After pasteurization, allow the straw to cool to a temperature suitable for inoculation (around 25-30°C). This process ensures that harmful competitors are minimized while maintaining the straw's integrity and nutrient content. Properly pasteurized straw provides an ideal environment for oyster mushroom mycelium to thrive.
In summary, for oyster mushroom cultivation, pasteurization is the recommended method over sterilization. It effectively reduces contaminants while preserving the straw's structure and beneficial microbial activity, which supports mycelium growth. Sterilization, though more thorough, is unnecessary for oyster mushrooms and can be impractical due to its higher costs and energy requirements. By mastering the pasteurization process, growers can create an optimal substrate for healthy and productive oyster mushroom cultivation.
Microdosing Mushrooms: Legal or Not?
You may want to see also

Benefits of Pasteurized Straw
When growing oyster mushrooms, using pasteurized straw as a substrate offers several significant advantages over untreated straw. Pasteurization is a process that involves heating the straw to a specific temperature to kill competing microorganisms, weeds, and pests without damaging its structure. This step is crucial for creating an optimal environment for mushroom mycelium to thrive. One of the primary benefits of pasteurized straw is that it eliminates unwanted bacteria, fungi, and spores that could compete with the oyster mushroom mycelium for nutrients. By reducing competition, the mycelium can colonize the straw more efficiently, leading to faster growth and higher yields of mushrooms.
Another key benefit of pasteurized straw is its ability to provide a clean and sterile medium for mushroom cultivation. Untreated straw may harbor pathogens or pests that can contaminate the growing environment, potentially leading to crop failure. Pasteurization ensures that the straw is free from harmful organisms, minimizing the risk of contamination and disease. This is particularly important for small-scale or indoor mushroom growers who may not have the resources to deal with outbreaks of pests or diseases. A clean substrate also promotes healthier mycelium, resulting in robust and high-quality mushroom fruiting bodies.
Pasteurized straw also retains its nutritional value while becoming more accessible to the mushroom mycelium. The heating process breaks down some of the straw's complex fibers, making it easier for the mycelium to digest and absorb nutrients. This enhanced nutrient availability supports vigorous mycelial growth and can lead to larger, more abundant mushroom harvests. Additionally, pasteurization can help neutralize any chemicals or residues present in the straw, ensuring a safer and more organic growing medium for edible mushrooms like oysters.
For growers concerned about consistency and predictability, pasteurized straw offers a more reliable substrate compared to untreated alternatives. Since the pasteurization process is controlled, the resulting straw has a consistent quality that supports uniform mycelial colonization and mushroom development. This reliability is especially valuable for commercial growers who need to plan and manage their harvests efficiently. By using pasteurized straw, growers can reduce the variability often associated with natural substrates and achieve more consistent results across batches.
Lastly, pasteurized straw contributes to better moisture retention, which is essential for oyster mushroom cultivation. The structure of pasteurized straw allows it to hold moisture more effectively, creating a stable and humid environment that mushrooms require for fruiting. Proper moisture levels are critical during the pinning and fruiting stages, and pasteurized straw helps maintain these conditions without becoming waterlogged. This balance ensures that the mycelium remains healthy and productive, ultimately leading to successful mushroom cultivation. In summary, pasteurizing straw for oyster mushrooms provides numerous benefits, including reduced competition, a cleaner growing medium, improved nutrient availability, consistency, and better moisture retention, all of which contribute to healthier mycelium and more abundant harvests.
Mushroom Capsules: Nature's Powerful Health Boost
You may want to see also

Alternative Substrates for Mushrooms
When cultivating oyster mushrooms, straw is a commonly used substrate, but it’s not the only option. Alternative substrates can be equally effective and may offer unique advantages depending on availability, cost, and environmental impact. One key consideration when using any substrate, including straw, is whether pasteurization is necessary. Pasteurization helps eliminate competing microorganisms, but some alternative substrates may require different preparation methods. For example, materials like coffee grounds, cardboard, or wood chips often need pasteurization or sterilization to ensure a clean environment for mushroom growth. However, certain substrates, such as spent brewery grains or fresh agricultural waste, may already be free of contaminants due to their processing methods, reducing the need for pasteurization.
Coffee grounds are a popular alternative substrate for oyster mushrooms, especially for urban growers. They are rich in nutrients and often readily available from local coffee shops. To prepare coffee grounds, mix them with a small amount of straw or cardboard to improve aeration, and pasteurize the mixture by soaking it in hot water (160-180°F) for an hour. This process kills unwanted bacteria and fungi while retaining enough beneficial microbes for mushroom colonization. Coffee grounds also have the added benefit of recycling waste, making them an eco-friendly choice.
Another viable substrate is cardboard, which is abundant and often free. Cardboard is primarily composed of cellulose, a material oyster mushrooms can easily break down. To use cardboard, tear it into small pieces, soak it in water, and pasteurize it by boiling or steaming. Alternatively, you can skip pasteurization if the cardboard is clean and free of inks or adhesives, though this carries a higher risk of contamination. Cardboard’s structure provides excellent air pockets, promoting healthy mycelium growth.
Wood chips or sawdust are also excellent substrates, particularly for outdoor cultivation. These materials are high in lignin, which oyster mushrooms can decompose efficiently. However, wood-based substrates typically require sterilization rather than pasteurization to eliminate all competing organisms. Sterilization involves heating the substrate to high temperatures (212°F or above) using a pressure cooker or autoclave. While this method is more labor-intensive, it ensures a sterile environment for optimal mushroom growth.
For those seeking low-cost options, agricultural waste like corn stalks, sugarcane bagasse, or even cottonseed hulls can be used. These materials often require pasteurization to reduce microbial competition, but their abundance and low cost make them attractive alternatives. Mixing these substrates with straw or supplementing them with nutrients like gypsum can enhance their suitability for oyster mushrooms. Always ensure the waste is free of pesticides or chemicals before use.
In conclusion, while straw is a traditional substrate for oyster mushrooms, numerous alternatives exist, each with its own preparation requirements. Pasteurization or sterilization is often necessary to create a clean environment, but some substrates may bypass this step depending on their source and condition. By experimenting with materials like coffee grounds, cardboard, wood chips, or agricultural waste, growers can find sustainable and effective alternatives tailored to their resources and needs.
The Origin of Stuffed Mushrooms: A Culinary Adventure
You may want to see also
Explore related products

Pasteurization Techniques for Straw
When growing oyster mushrooms, pasteurizing straw is a crucial step to ensure a successful harvest. Pasteurization helps eliminate unwanted microorganisms, weeds, and pests that could compete with the mushroom mycelium for nutrients. While it is possible to use untreated straw, pasteurization significantly reduces the risk of contamination and improves the overall yield. There are several techniques to pasteurize straw, each with its own advantages and considerations.
Hot Water Bath Pasteurization is one of the most common methods used by mushroom cultivators. To implement this technique, submerge the straw in hot water (around 60-70°C or 140-158°F) for 1-2 hours. This process kills most competing organisms while preserving the straw's structure and nutrients. After the bath, drain the straw and allow it to cool before inoculating it with mushroom spawn. It’s essential to monitor the water temperature to avoid overheating, which can degrade the straw’s quality.
Steam Pasteurization is another effective method, particularly for larger-scale operations. In this technique, steam is applied directly to the straw, raising its temperature to around 70-80°C (158-176°F) for 1-2 hours. Steam pasteurization is more efficient than a hot water bath as it heats the straw more uniformly and quickly. However, it requires specialized equipment like a steam generator or a large steamer, making it less accessible for small-scale growers.
Chemical Pasteurization involves treating straw with chemicals like lime (calcium hydroxide) or hydrogen peroxide. For example, soaking straw in a lime solution (2-3% concentration) for 12-24 hours can effectively kill contaminants. While chemical methods are simpler and require less energy, they can alter the straw’s pH or leave residues, potentially affecting mycelium growth. This method is less commonly used compared to heat-based techniques.
Solar Pasteurization is an eco-friendly and low-cost alternative, ideal for small-scale growers in sunny regions. To solar pasteurize, place the straw in a clear plastic bag and leave it in direct sunlight for 3-7 days. The greenhouse effect inside the bag raises the temperature sufficiently to kill most contaminants. However, this method is weather-dependent and may not achieve consistent results in cooler or cloudy climates.
Choosing the right pasteurization technique depends on factors like scale, available resources, and environmental conditions. Regardless of the method, proper hydration and sterilization of equipment are essential to prevent recontamination. Pasteurized straw should be used within 24-48 hours for best results, ensuring a clean and nutrient-rich substrate for oyster mushroom cultivation.
The Magic of Mushroom Cloning: Dried Revival
You may want to see also

Risks of Untreated Straw
When growing oyster mushrooms, using untreated straw as a substrate can introduce several risks that may compromise the success of your mushroom cultivation. One of the primary concerns is the presence of competing microorganisms, such as bacteria and molds, which naturally inhabit straw. These organisms can outcompete the mushroom mycelium for nutrients, leading to poor colonization and reduced yields. Without pasteurization, the straw remains a fertile ground for these competitors, making it difficult for the oyster mushroom mycelium to establish dominance.
Another significant risk of using untreated straw is the potential for contamination by pests and pathogens. Straw can harbor insects, mites, and their eggs, which can infest your mushroom grow area. Additionally, harmful fungi or bacteria present in the straw may produce toxins or diseases that negatively affect mushroom growth. Pasteurization eliminates these pests and pathogens, ensuring a cleaner and safer environment for the mycelium to thrive. Ignoring this step increases the likelihood of crop failure or the production of subpar mushrooms.
Untreated straw also retains a high microbial load, which can lead to unwanted fermentation or overheating during the incubation phase. As the mycelium grows, the substrate temperature may rise due to metabolic activity. If the straw is not pasteurized, the existing microorganisms can exacerbate this heating, potentially killing the mycelium or creating anaerobic conditions that hinder growth. Pasteurization reduces this microbial load, minimizing the risk of overheating and ensuring a more stable environment for mushroom development.
Furthermore, untreated straw may contain weed seeds or other plant material that can germinate and compete with the mushroom mycelium for resources. These weeds can quickly take over the substrate, depriving the mycelium of essential nutrients and space. Pasteurization not only kills these seeds but also breaks down complex organic matter, making nutrients more accessible to the mushroom mycelium. Skipping this process can result in a substrate that is less conducive to mushroom growth and more prone to unwanted vegetation.
Lastly, using untreated straw increases the risk of introducing foreign spores or contaminants into your grow environment. These contaminants can come from the field where the straw was harvested or from storage conditions. Once introduced, they can persist and affect future batches, even if you switch to pasteurized straw. Pasteurization acts as a critical biosecurity measure, reducing the likelihood of cross-contamination and ensuring a more consistent and reliable mushroom cultivation process. Given these risks, pasteurizing straw is a crucial step for anyone serious about successfully growing oyster mushrooms.
Mushroom Hunting: Are Odd Ones Worth the Risk?
You may want to see also
Frequently asked questions
Yes, pasteurizing straw is necessary for growing oyster mushrooms to eliminate competing organisms and create a clean substrate for mycelium growth.
No, even fresh and clean straw can harbor bacteria, fungi, and pests that may outcompete the oyster mushroom mycelium, so pasteurization is still recommended.
The easiest method is soaking the straw in hot water (60-70°C or 140-158°F) for 1-2 hours, then draining and cooling it before inoculation.
No, pasteurization is designed to kill competing organisms while keeping the straw viable for oyster mushroom mycelium to colonize. Proper temperatures and timing ensure the straw remains suitable for growth.